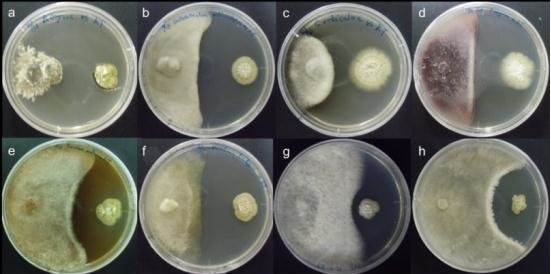

گروه کشاورزی مجتمع آموزش عالی میناب شامل 4 رشته و گرایش می باشد که در ذیل توضیح مختصری راجع به آن ها آورده شده است.
علوم و مهندسی باغبانی
این رشته تلفیقی از علوم، هنر، تکنیک و فناوریهای مرتبط با کاشت، داشت و برداشت، فرآوری و فروش انواع گلها و گیاهان زینتی، میوهها، سبزیها و گیاهان دارویی و معطر است. همچنین مطالعه و یافتن روشهایی برای بهبود عمر پس از برداشت محصولات مختلف باغی و به نژادی و معرفی ارقام جدید از دیگر خدمات این رشته مهم علوم کشاورزی به حساب میآید.
با توجه به اینکه سهم بسیار زیادی از اشتغال در بخش کشاورزی به تولید و فروش محصولات باغبانی مربوط است و از طرفی با افزایش روز افزون جمعیت کشور مواجه هستیم، نیاز به تربیت نیروی انسانی تحصیل کرده در حوزه کشاورزی، کمک بسیار زیادی به افزایش تولید و اصلاح محصولات باغبانی خواهد کرد. مهمترین ویژگی اغلب محصولات باغبانی این است که به صورت تازه و با کمترین تغییر و تبدیل مورد استفاده انسان قرار میگیرند. هدف از آموزش در رشته رشته علوم و مهندسی باغبانی تربیت کارشناسانی است که به دانش روز مجهز بوده و بتوانند با تأکید بر حفظ محیط زیست در جهت بالا بردن کمیت و کیفیت محصولات، احداث باغ، نگهداری و توسعه محصولات باغی موثر باشند.


مهندسی تولید و ژنتیک گیاهی
رشته مهندسی تولید و ژنتیک گیاهی، یکی از شاخههای مجموعه مهندسی کشاورزی است که بر پایه "به کارگیری اصول علوم زراعی و ژنتیک در تولید محصولات غذایی" استوار است. این رشته بر حفظ منابع طبیعی، محیط زیست و بهرهبرداری مطلوب از نهادههای کشاورزی استوار است. آموزش نیروی انسانی متخصص جهت توسعه کشاورزی به ویژه در زمینههای کاشت، داشت و برداشت انواع گیاهان زراعی و صنعتی، همچنین زیست فناوری، کشت بافت، انتقال ژن و توسعه کشاورزی پایدار و ارگانیک از اهداف این رشته به حساب میآید.
دانشآموختگان رشته مهندسی تولید و ژنتیک گیاهی میتوانند در زمینههای متنوعی وارد بازار کار شوند به عنوان مثال طراحی و نظارت بر سیستمهای کشت در مزارع و گلخانهها، مدیریت یا اجرا در واحدهای تولیدی دولتی و خصوصی کشاورزی، به عنوان کارشناس و برنامهریز متخصص در شرکتهای خصوصی یا سازمانهای دولتی فعال در بخش کشاورزی.

مهندسی فضای سبز
یک تخصص بین رشتهای و تلفیقی هنرمندانه از مهندسي معماري، مهندسي علوم باغباني و مهندسي عمران و شهرسازي است. بخش قابل توجهی از فعالیتهای اين رشته در ارتباط با معماري و باغباني زينتي انجام میشود و از آنجا که به معماري منظر بسيار نزديک است گاهی از آن با عنوان مهندسي طراحي منظر ياد ميشود.
این رشته با ایجاد فضای سبز در سطح شهرها، کاشت درختان در حاشیه خيابانها، احداث انواع پارکهاي جنگلي، کوهستاني و منطقهاي، فضاسازي و زيباسازي، کاهش آلودگيهاي بصري، تقليل صداهاي آزار دهنده و تعديل آلودگيهاي صوتي، حفاظت و صيانت از محيط طبيعي و منابع موجود در آن و حفاظت از تنوع زیستی، باعث حفظ فضاي سبز، سلامت و زيبايي سكونتگاههاي انسانی شده و نياز ما را به فضاي سبز موردنظر تأمين ميكند.
هدف از تأسیس این رشته تربیت کارشناسانی است که بتوانند در جهت شناسایی مطلوب شرایط محیطزیست شهرها و مناطق صنعتی، با بهرهگیری از اصول طراحی و مدیریت فضاهای سبز در جهت بهبود کیفی اینگونه محیطها برنامهریزی و اقدام کنند. به بیان دیگر هدف مهندسی فضای سبز علاوه بر زیباسازی محیط، بهبودی شرایط زیستی انسان در محیطهای تنشزای جوامع صنعتی است.


گیاهپزشکی
دانش گیاهپزشکی ترکیبی از علوم گوناگون است. این رشته به سلامت گیاهان میپردازد و با بررسی و شناسایی آفات و عوامل بیماریزای گیاهی و همچنین اصول و روشهای کنترل این عوامل، به بهبود محصولات کشاورزی کمک مینماید. در واقع هدف اساسی این رشته، کاهش میزان خسارت کمی و کیفی عوامل خسارتزای کشاورزی و تأمین و حفاظت محصولات گیاهی است.
فعالیت به عنوان کارشناس اجرایی یا تحقیقاتی در مؤسسههای مختلف دولتی و خصوصی بخش کشاورزی، مراکز پژوهشی، سازمانهای دولتی و نیمه دولتی (مانند سازمان جنگلها، مراتع و آبخیزداری و ادارات جهاد کشاورزی و منابع طبیعی، سازمان بوستانها و فضای سبز، شهرداریها، سازمان حفاظت محیط زیست و…) و بخشهای غیردولتی شامل کلینیکهای خصوصی گیاهپزشکی و شرکتهای توزیع کود و سم، از مهمترین حوزههای اشتغال برای دانشآموختگان رشته گیاهپزشکی میباشد.
همچنین امکان ادامه تحصیل در رشته گیاهپزشکی تا مقطع دکتری در داخل کشور وجود دارد. مقطع کارشناسی ارشد این رشته شامل حشرهشناسی کشاورزی و بیماریشناسی گیاهی میشود. عمده فعالیتهای تحقیقاتی اساتید گیاهپزشکی مجتمع آموزش عالی میناب، دانشگاه هرمزگان شامل برهمکنش میکروب-گیاه، ویروسهای گیاهی، استفاده از ترکیبات طبیعی در جهت کنترل عوامل بیماریزای گیاهی و انسانی، آفتکشهای زیستی، برهمکنش ویروس و فیتوپلاسما با ناقلین حشرهای و بیماریهای فیتوپلاسمایی است.




مهندسی صنایع غذایی
رشته مهندسی صنایع غذایی را میتوان یک مرحله بعد از تولید محصولات کشاورزی و علم تبدیل این فراوردههای خام به محصولات متنوع غذایی که در فروشگاهها و مراکز توزیع عرضه میشود دانست. این رشته ترکیبی از علوم مهندسی، شیمی و زیستشناسی است که به بررسی، طراحی و بهینهسازی فرآیندهای تولید، نگهداری و بستهبندی مواد غذایی میپردازد. دانشجویان در طول تحصیل با اصول مهندسی مواد غذایی، کنترل کیفیت، میکروبیولوژی، بهداشت و ایمنی غذا آشنا میشوند. اهمیت این رشته بهویژه در دنیای امروز که نیاز به تولید انبوه، حفظ ارزش غذایی و کاهش ضایعات حیاتی است، بسیار بالاست.
فارغالتحصیلان این رشته میتوانند در کارخانههای صنایع غذایی، شرکتهای بستهبندی، آزمایشگاههای کنترل کیفیت، مراکز تحقیقاتی، سازمان استاندارد، وزارت بهداشت و مراکز مرتبط دیگر در حوزه تولید مواد غذایی فعالیت کنند. از جمله سمت های متخصصین صنایع غذایی در هر کارخانه یا سازمان مرتبط با تولید، بسته بندی، پخش، عرضه و واردات صادرات مواد غذایی میتوان به مواردی مانند مدیر تولید، مسئول فنی، مسئول آزمایشگاه، مسئول کنترل کیفیت، مسئول بخش تحقیق و توسعه، مشاور، ناظر و ... اشاره کرد.
از طرفی دیگر رشته صنایع غذایی ذاتا رشتهای با قابلیت بالا در امکان کارآفرینی و خوداشتغالی در بین فارغالتحصیلان آن میباشد و با تکیه بر پتاسیلهای بومی هر منطقه امکان راهاندازی مشاغل مختلف در سطوح خرد، کارگاهی و صنعتی فراهم است.
رشته صنایع غذایی در مقاطع کارشناسی ارشد و دکترا در چهار گرایش شامل صنایع غذایی، شیمی مواد غذایی، فناوری مواد غذایی و زیست فناوری مواد غذایی در بسیاری از دانشگاههای برتر کشور ارائه میشود.
در مجموع با توجه به رشد جمعیت و نیاز جهانی به مواد غذایی سالم، آینده شغلی این رشته روشن و رو به توسعه است.


آخرین ویرایش 10 خرداد 1404
5 1
بازدید امروز: 15 بازدید کل: 14438